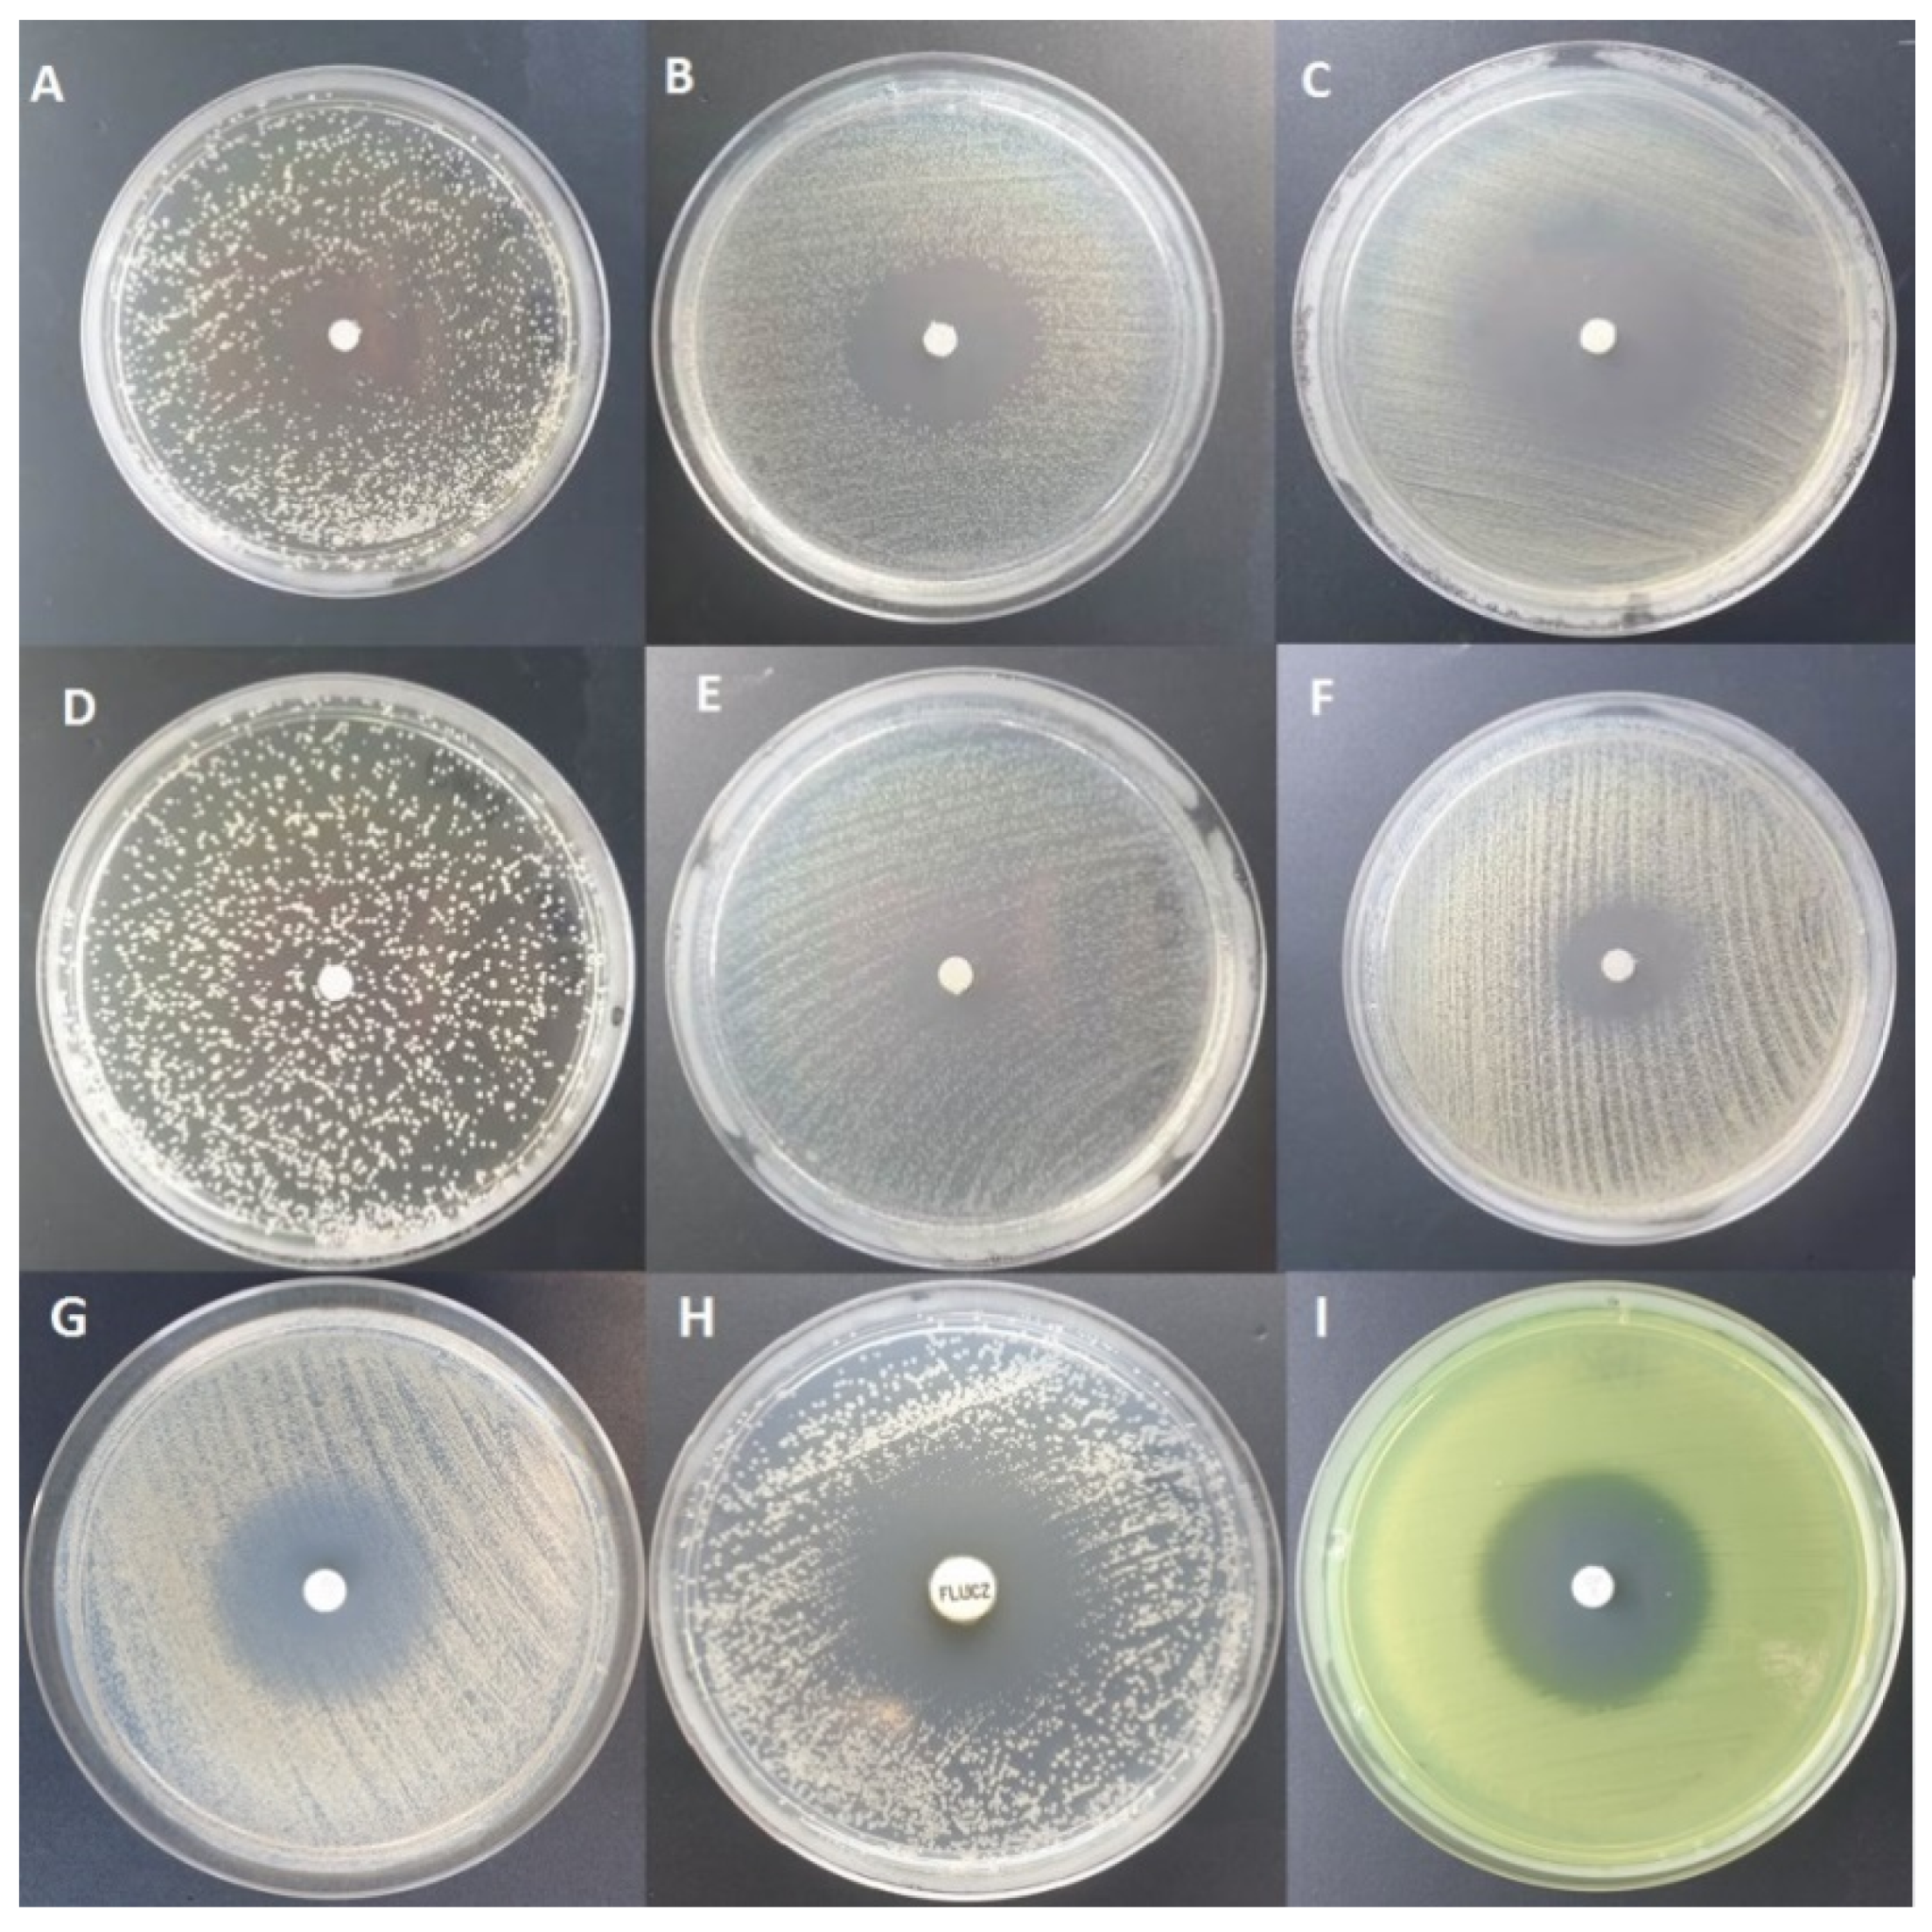
Pathogens 10 00515 g001 Pathogens 10 00515 g001

Activity of Liquid and Volatile Fractions of Essential Oils against Biofilm Formed by Selected Reference Strains on Polystyrene and Hydroxyapatite Surfaces
Abstract
1. Introduction
2. Results
2.1. Evaluation of Antimicrobial Activity of Tested Essential Oils Using Disc Diffusion Method
- S. aureus: F-EO (0 mm) < CW-EO (1 mm) < C-EO (7 mm) < OCT (8 mm) < G-EO(9 mm) < Tt-EO(16 mm) < ATB(16)
- E. faecalis: F-EO (0 mm) < CW-EO (1 mm) < G-EO (6 mm) < C-EO (7 mm) < OCT (7.33 mm) < ATB (12 mm) < Tt-EO (16 mm)
- P. aeruginosa: F-EO (0 mm) < CW-EO (1 mm) < C-EO (6 mm) < G-EO (7 mm) = Tt-EO (7 mm) < OC (7.66 mm)T < ATB (32 mm)
- K. pneumoniae: F-EO (0 mm) < CW-EO (1 mm) < C-EO (6 mm) < OCT (7.66 mm) < G-EO (8.33 mm) < Tt-EO (11.66 mm) < ATB (23 mm)
- E. coli: F-EO (0 mm) < CW-EO (1 mm) < C-EO (6 mm) = G-EO (6 mm) < OCT (7.66 mm) < Tt-EO (12.66 mm) < ATB (38 mm)
- C. albicans: CW-EO (1 mm) < G-EO (6 mm) < OCT (8 mm) < C-EO (7 mm) < Tt-EO (18 mm) < F-EO (25 mm) < ATB (26 mm)
2.2. Evaluation of the Minimum Inhibitory Concentration (MIC) of EOs and EO Emulsions with Tween 20 Using Serial Microdilution Mmethod in a 96-well Plate
2.3. Evaluation of the Minimum Biofilm Eradication Concentration (MBEC) of EOs and EO Emulsions
2.4. Modified Antibiofilm Dressing Activity Measurement Assay Results
2.5. AntiBioVol Test Results
3. Discussion
4. Materials and Methods
4.1. Bacterial and Fungal Strains
- Staphylococcus aureus 6538: human lesion
- E. faecalis 2912, K. pneumoniae 700603: urine from hospitalized patient
- E.coli 25992: clinical isolate
- C. albicans 10231: bronchomycosis
4.2. Essential Oils and Reference Substances
4.3. In Vitro Analysis
4.3.1. Evaluation of Antimicrobial Activity of Tested Essential Oils Using Disc Diffusion Method
4.3.2. Evaluation of the Minimum Inhibitory Concentration (MIC) of EOs or EO Emulsion with Tween 20 Using Serial Microdilution Method
4.3.3. Evaluation of the Minimum Biofilm Eradication Concentration (MBEC) of EOs and EO Emulsion with Tween 20 Using a Serial Microdilution Method
4.3.4. Modified A.D.A.M. Assay (Modification of Antibiofilm Dressing’s Activity Measurement)
4.3.5. AntiBioVol Measurement of Antibiofilm Activity of Volatile Compounds
4.4. Gas Chromatography-Mass Spectrometry Analysis
GC-MS Analysis of the Tested EOs Composition
4.5. Statistical Analysis
5. Conclusions
- The antimicrobial potency of EOs’ volatile fraction against biofilm formed by opportunistic pathogens differs from that of the liquid fraction.
- The activity of EOs’ volatile fraction may depend on the setting used in laboratory analysis.
- The activity of volatile fraction compounds is related to their molecular weight.
- The addition of Tween 20 to the liquid fractions of the studied EOs did not enhance their ability to eradicate the biofilm.
- Further analyses and implementation of obtained in vitro data may open a new path in the application of EOs against biofilms formed in vivo.
Supplementary Materials
Author Contributions
Funding
Institutional Review Board Statement
Informed Consent Statement
Data Availability Statement
Acknowledgments
Conflicts of Interest
References
- Verderosa, A.D.; Totsika, M.; Fairfull-Smith, K.E. Bacterial Biofilm Eradication Agents: A Current Review. Front. Chem. 2019, 7, 824. [Google Scholar] [CrossRef]
- Römling, U.; Kjelleberg, S.; Normark, S.; Nyman, L.; Uhlin, B.E.; Åkerlund, B. Microbial biofilm formation: A need to act. J. Intern. Med. 2014, 276, 98–110. [Google Scholar] [CrossRef] [PubMed]
- Rabin, N.; Zheng, Y.; Opoku-Temeng, C.; Du, Y.; Bonsu, E.; Sintim, H.O. Biofilm formation mechanisms and targets for developing antibiofilm agents. Futur. Med. Chem. 2015, 7, 493–512. [Google Scholar] [CrossRef] [PubMed]
- Chen, L.; Wen, Y. The role of bacterial biofilm in persistent infections and control strategies. Int. J. Oral Sci. 2011, 3, 66–73. [Google Scholar] [CrossRef]
- Bi, Y.; Xia, G.; Shi, C.; Wan, J.; Liu, L.; Chen, Y.; Wu, Y.; Zhang, W.; Zhou, M.; He, H.; et al. Therapeutic strategies against bacterial biofilms. Fundam. Res. 2021, 1, 193–212. [Google Scholar] [CrossRef]
- Zhang, K.; Li, X.; Yu, C.; Wang, Y. Promising Therapeutic Strategies Against Microbial Biofilm Challenges. Front. Cell. Infect. Microbiol. 2020, 10, 359. [Google Scholar] [CrossRef]
- Li, X.-H.; Lee, J.-H. Antibiofilm agents: A new perspective for antimicrobial strategy. J. Microbiol. 2017, 55, 753–766. [Google Scholar] [CrossRef]
- Stringaro, A.; Colone, M.; Angiolella, L. Antioxidant, Antifungal, Antibiofilm, and Cytotoxic Activities of Mentha spp. Essential Oils. Medicines 2018, 5, 112. [Google Scholar] [CrossRef]
- Thielmann, J.; Muranyi, P.; Kazman, P. Screening essential oils for their antimicrobial activities against the foodborne pathogenic bacteria Escherichia coli and Staphylococcus aureus. Heliyon 2019, 5, e01860. [Google Scholar] [CrossRef] [PubMed]
- Zhang, X.; Guo, Y.; Guo, L.; Jiang, H.; Ji, Q. In Vitro Evaluation of Antioxidant and Antimicrobial Activities of Melaleuca alternifolia Essential Oil. BioMed Res. Int. 2018, 2018, 1–8. [Google Scholar] [CrossRef]
- Ács, K.; Balázs, V.L.; Kocsis, B.; Bencsik, T.; Böszörményi, A.; Horváth, G. Antibacterial activity evaluation of selected essential oils in liquid and vapor phase on respiratory tract pathogens. BMC Complement. Altern. Med. 2018, 18, 227. [Google Scholar] [CrossRef] [PubMed]
- Wińska, K.; Mączka, W.; Łyczko, J.; Grabarczyk, M.; Czubaszek, A.; Szumny, A. Essential Oils as Antimicrobial Agents—Myth or Real Alternative? Molecules 2019, 24, 2130. [Google Scholar] [CrossRef] [PubMed]
- Brun, P.; Bernabè, G.; Filippini, R.; Piovan, A. In Vitro Antimicrobial Activities of Commercially Available Tea Tree (Melaleuca alternifolia) Essential Oils. Curr. Microbiol. 2019, 76, 108–116. [Google Scholar] [CrossRef]
- Fani, M.; Kohanteb, J. In Vitro Antimicrobial Activity of Thymus vulgaris Essential Oil Against Major Oral Pathogens. J. Evidence-Based Integr. Med. 2017, 22, 660–666. [Google Scholar] [CrossRef] [PubMed]
- Brożyna, M.; Żywicka, A.; Fijałkowski, K.; Gorczyca, D.; Oleksy-Wawrzyniak, M.; Dydak, K.; Migdał, P.; Dudek, B.; Bartoszewicz, M.; Junka, A. The Novel Quantitative Assay for Measuring the Antibiofilm Activity of Volatile Compounds (AntiBioVol). Appl. Sci. 2020, 10, 7343. [Google Scholar] [CrossRef]
- Hriouech, S.; Akhmouch, A.A.; Mzabi, A.; Chefchaou, H.; Tanghort, M.; Oumokhtar, B.; Chami, N.; Remmal, A. The Antistaphylococcal Activity of Amoxicillin/Clavulanic Acid, Gentamicin, and 1,8-Cineole Alone or in Combination and Their Efficacy through a Rabbit Model of Methicillin-Resistant Staphylococcus aureus Osteomyelitis. Evid. Based Complement. Altern. Med. 2020, 2020, 1–9. [Google Scholar] [CrossRef]
- Van Vuuren, S.; Viljoen, A. Interaction between the non-volatile and volatile fractions on the antimicrobial activity of Tarchonanthus camphoratus. S. Afr. J. Bot. 2009, 75, 505–509. [Google Scholar] [CrossRef]
- Cáceres, M.; Hidalgo, W.; Stashenko, E.; Torres, R.; Ortiz, C. Essential Oils of Aromatic Plants with Antibacterial, Anti-Biofilm and Anti-Quorum Sensing Activities against Pathogenic Bacteria. Antibiotics 2020, 9, 147. [Google Scholar] [CrossRef]
- Kerekes, E.B.; Vidács, A.; Takó, M.; Petkovits, T.; Vágvölgyi, C.; Horváth, G.; Balázs, V.L.; Krisch, J. Anti-Biofilm Effect of Selected Essential Oils and Main Components on Mono- and Polymicrobic Bacterial Cultures. Microorganisms 2019, 7, 345. [Google Scholar] [CrossRef]
- Kavanaugh, N.L.; Ribbeck, K. Selected Antimicrobial Essential Oils Eradicate Pseudomonas spp. and Staphylococcus aureus Biofilms. Appl. Environ. Microbiol. 2012, 78, 4057–4061. [Google Scholar] [CrossRef] [PubMed]
- Lebeaux, D.; Ghigo, J.-M.; Beloin, C. Biofilm-Related Infections: Bridging the Gap between Clinical Management and Fundamental Aspects of Recalcitrance toward Antibiotics. Microbiol. Mol. Biol. Rev. 2014, 78, 510–543. [Google Scholar] [CrossRef]
- Masters, E.A.; Trombetta, R.P.; Bentley, K.L.D.M.; Boyce, B.F.; Gill, A.L.; Gill, S.R.; Nishitani, K.; Ishikawa, M.; Morita, Y.; Ito, H.; et al. Evolving concepts in bone infection: Redefining “biofilm”, “acute vs. chronic osteomyelitis”, “the immune proteome” and “local antibiotic therapy”. Bone Res. 2019, 7, 1–18. [Google Scholar] [CrossRef] [PubMed]
- Arciola, C.; An, Y.; Campoccia, D.; Donati, M.; Montanaro, L. Etiology of Implant Orthopedic Infections: A Survey on 1027 Clinical Isolates. Int. J. Artif. Organs 2005, 28, 1091–1100. [Google Scholar] [CrossRef]
- Ma, X.; Han, S.; Ma, J.; Chen, X.; Bai, W.; Yan, W.; Wang, K. Epidemiology, microbiology and therapeutic consequences of chronic osteomyelitis in northern China: A retrospective analysis of 255 Patients. Sci. Rep. 2018, 8, 14895. [Google Scholar] [CrossRef]
- Mulleman, D.; Philippe, P.; Senneville, E.; Costes, C.; Fages, L.; Deprez, X.; Flipo, R.-M.; Duquesnoy, B. Streptococcal and enterococcal spondylodiscitis (vertebral osteomyelitis). High incidence of infective endocarditis in 50 cases. J. Rheumatol. 2006, 33, 91–97. [Google Scholar] [PubMed]
- Prokesch, B.C.; TeKippe, M.; Kim, J.; Raj, P.; TeKippe, E.M.; Greenberg, D.E. Primary osteomyelitis caused by hypervirulent Klebsiella pneumoniae. Lancet Infect. Dis. 2016, 16, e190–e195. [Google Scholar] [CrossRef]
- Shahi, S.K.; Singh, V.K.; Kumar, A. Detection of Escherichia coli and Associated β-Lactamases Genes from Diabetic Foot Ulcers by Multiplex PCR and Molecular Modeling and Docking of SHV-1, TEM-1, and OXA-1 β-Lactamases with Clindamycin and Piperacillin-Tazobactam. PLoS ONE 2013, 8, e68234. [Google Scholar] [CrossRef]
- Lobati, F.; Herndon, B.; Bamberger, D. Osteomyelitis: Etiology, diagnosis, treatment and outcome in a public versus a private institution. Infection 2001, 29, 333–336. [Google Scholar] [CrossRef] [PubMed]
- Luey, C.; Tooley, D.; Briggs, S. Emphysematous osteomyelitis: A case report and review of the literature. Int. J. Infect. Dis. 2012, 16, e216–e220. [Google Scholar] [CrossRef] [PubMed]
- Hamzaoui, A.; Salem, R.; Koubaa, M.; Zrig, M.; Mnif, H.; Abid, A.; Golli, M.; Mahjoub, S. Escherichia coli osteomyelitis of the ischium in an adult. Orthop. Traumatol. Surg. Res. 2009, 95, 636–638. [Google Scholar] [CrossRef] [PubMed]
- Goyal, A.; Khanduri, S.; Singh, M.; Singh, S. Emphysematous osteomyelitis: Report of two cases and review of literature. Indian J. Radiol. Imaging 2018, 28, 78–80. [Google Scholar] [CrossRef]
- Matsuura, H.; Sue, M.; Takahara, M.; Kuninaga, N. Escherichia coli rib osteomyelitis. Int. J. Med. 2018, 112, 35–36. [Google Scholar] [CrossRef]
- Lee, J.; Jeong, C.H.; Lee, M.H.; Jeong, E.-G.; Kim, Y.J.; Kim, S.I.; Kim, Y.R. Emphysematous Osteomyelitis due to Escherichia coli. Infect. Chemother. 2017, 49, 151–154. [Google Scholar] [CrossRef]
- Ceroni, D.; Grumetz, C.; Desvachez, O.; Pusateri, S.; Dunand, P.; Samara, E. From prevention of pin-tract infection to treatment of osteomyelitis during paediatric external fixation. J. Child. Orthop. 2016, 10, 605–612. [Google Scholar] [CrossRef] [PubMed]
- Cha, J.-G.; Hong, H.-S.; Koh, Y.-W.; Kim, H.-K.; Park, J.-M. Candida albicans osteomyelitis of the cervical spine. Skelet. Radiol. 2008, 37, 347–350. [Google Scholar] [CrossRef] [PubMed]
- Gamaletsou, M.N.; Kontoyiannis, D.P.; Sipsas, N.V.; Moriyama, B.; Alexander, E.; Roilides, E.; Brause, B.; Walsh, T.J. Candida Osteomyelitis: Analysis of 207 Pediatric and Adult Cases (1970–2011). Clin. Infect. Dis. 2012, 55, 1338–1351. [Google Scholar] [CrossRef] [PubMed]
- Magano, R.; Cortez, J.; Ramos, E.; Trindade, L. Candida albicansosteomyelitis as a cause of chest pain and visual loss. BMJ Case Rep. 2015, 2015. [Google Scholar] [CrossRef]
- Wisplinghoff, H.; Bischoff, T.; Tallent, S.M.; Seifert, H.; Wenzel, R.P.; Edmond, M.B. Nosocomial Bloodstream Infections in US Hospitals: Analysis of 24,179 Cases from a Prospective Nationwide Surveillance Study. Clin. Infect. Dis. 2004, 39, 309–317. [Google Scholar] [CrossRef]
- Fei, C.; Mao, S.; Yan, J.; Alert, R.; Stone, H.A.; Bassler, B.L.; Wingreen, N.S.; Košmrlj, A. Nonuniform growth and surface friction determine bacterial biofilm morphology on soft substrates. Proc. Natl. Acad. Sci. USA 2020, 117, 7622–7632. [Google Scholar] [CrossRef]
- Paula, A.J.; Hwang, G.; Koo, H. Dynamics of bacterial population growth in biofilms resemble spatial and structural aspects of urbanization. Nat. Commun. 2020, 11, 1–14. [Google Scholar] [CrossRef]
- Hood, J.R.; Wilkinson, J.M.; Cavanagh, H.M. Evaluation of Common Antibacterial Screening Methods Utilized in Essential Oil Research. J. Essent. Oil Res. 2003, 15, 428–433. [Google Scholar] [CrossRef]
- Donaldson, J.R.; Warner, S.L.; Cates, R.G.; Young, D.G. Assessment of Antimicrobial Activity of Fourteen Essential Oils When Using Dilution and Diffusion Methods. Pharm. Biol. 2005, 43, 687–695. [Google Scholar] [CrossRef]
- Sharifi-Rad, J.; Sureda, A.; Tenore, G.C.; Daglia, M.; Sharifi-Rad, M.; Valussi, M.; Tundis, R.; Sharifi-Rad, M.; Loizzo, M.R.; Ademiluyi, A.O.; et al. Biological Activities of Essential Oils: From Plant Chemoecology to Traditional Healing Systems. Molecules 2017, 22, 70. [Google Scholar] [CrossRef]
- Tariq, S.; Wani, S.; Rasool, W.; Shafi, K.; Bhat, M.A.; Prabhakar, A.; Shalla, A.H.; Rather, M.A. A comprehensive review of the antibacterial, antifungal and antiviral potential of essential oils and their chemical constituents against drug-resistant microbial pathogens. Microb. Pathog. 2019, 134, 103580. [Google Scholar] [CrossRef]
- Bhalla, Y.; Gupta, V.K.; Jaitak, V. Anticancer activity of essential oils: A review. J. Sci. Food Agric. 2013, 93, 3643–3653. [Google Scholar] [CrossRef] [PubMed]
- Elansary, H.O.; Abdelgaleil, S.A.M.; Mahmoud, E.A.; Yessoufou, K.; Elhindi, K.; El-Hendawy, S. Effective antioxidant, antimicrobial and anticancer activities of essential oils of horticultural aromatic crops in northern Egypt. BMC Complement. Altern. Med. 2018, 18, 1–10. [Google Scholar] [CrossRef] [PubMed]
- Sugier, P.; Jakubowicz-Gil, J.; Sugier, D.; Kowalski, R.; Gawlik-Dziki, U.; Kołodziej, B.; Dziki, D. Chemical Characteristics and Anticancer Activity of Essential Oil from Arnica montana L. Rhizomes and Roots. Molecules 2020, 25, 1284. [Google Scholar] [CrossRef]
- Chouhan, S.; Sharma, K.; Guleria, S. Antimicrobial Activity of Some Essential Oils—Present Status and Future Perspectives. Medicines 2017, 4, 58. [Google Scholar] [CrossRef]
- De Castro, M.L.; Jiménez-Carmona, M.; Fernández-Pérez, V. Towards more rational techniques for the isolation of valuable essential oils from plants. TrAC Trends Anal. Chem. 1999, 18, 708–716. [Google Scholar] [CrossRef]
- Wu, C.; Lim, J.Y.; Fuller, G.G.; Cegelski, L. Disruption of Escherichia coli Amyloid-Integrated Biofilm Formation at the Air–Liquid Interface by a Polysorbate Surfactant. Langmuir 2012, 29, 920–926. [Google Scholar] [CrossRef] [PubMed]
- Ueda, Y.; Mashima, K.; Miyazaki, M.; Hara, S.; Takata, T.; Kamimura, H.; Takagi, S.; Jimi, S. Inhibitory effects of polysorbate 80 on MRSA biofilm formed on different substrates including dermal tissue. Sci. Rep. 2019, 9, 6792. [Google Scholar] [CrossRef]
- Donsì, F.; Annunziata, M.; Vincensi, M.; Ferrari, G. Design of nanoemulsion-based delivery systems of natural antimicrobials: Effect of the emulsifier. J. Biotechnol. 2012, 159, 342–350. [Google Scholar] [CrossRef]
- Nielsen, C.K.; Kjems, J.; Mygind, T.; Snabe, T.; Meyer, R.L. Effects of Tween 80 on Growth and Biofilm Formation in Laboratory Media. Front. Microbiol. 2016, 7, 1878. [Google Scholar] [CrossRef] [PubMed]
- Balouiri, M.; Sadiki, M.; Ibnsouda, S.K. Methods for in vitro evaluating antimicrobial activity: A review. J. Pharm. Anal. 2016, 6, 71–79. [Google Scholar] [CrossRef]
- Cos, P.; Vlietinck, A.J.; Berghe, D.V.; Maes, L. Anti-infective potential of natural products: How to develop a stronger in vitro ‘proof-of-concept’. J. Ethnopharmacol. 2006, 106, 290–302. [Google Scholar] [CrossRef] [PubMed]
- Venkatesh, H.N.; Sudharshana, T.N.; Abhishek, R.U.; Thippeswamy, S.; Manjunath, K.; Mohana, D.C. Antifungal and antimycotoxigenic properties of chemically characterised essential oil of Boswellia serrataRoxb. ex Colebr. Int. J. Food Prop. 2017, 20, 1–13. [Google Scholar] [CrossRef]
- Camarda, L.; Dayton, T.; Di Stefano, V.; Pitonzo, R.; Schillaci, D. Chemical Composition and Antimicrobial Activity of Some Oleogum Resin Essential Oils fromBoswellia SPP. (Burseraceae). Ann. Chim. 2007, 97, 837–844. [Google Scholar] [CrossRef]
- Sadhasivam, S.; Palanivel, S.; Ghosh, S. Synergistic antimicrobial activity ofBoswellia serrataRoxb. ex Colebr. (Burseraceae) essential oil with various azoles against pathogens associated with skin, scalp and nail infections. Lett. Appl. Microbiol. 2016, 63, 495–501. [Google Scholar] [CrossRef] [PubMed]
- Van Vuuren, S.; Kamatou, G.; Viljoen, A. Volatile composition and antimicrobial activity of twenty commercial frankincense essential oil samples. S. Afr. J. Bot. 2010, 76, 686–691. [Google Scholar] [CrossRef]
- Slifkin, M. Tween 80 Opacity Test Responses of VariousCandida Species. J. Clin. Microbiol. 2000, 38, 4626–4628. [Google Scholar] [CrossRef]
- Pospíšil, L.; Kabátová, A. Die lipolytische Aktivität einiger Candida-Arten. Zent. Bakteriol. Parasitenkd. Infekt. Hyg. Zweite Nat. Abt. Allg. Landwirtsch. Tech. Mikrobiol. 1976, 131, 692–696. [Google Scholar] [CrossRef]
- Essid, R.; Hammami, M.; Gharbi, D.; Karkouch, I.; Ben Hamouda, T.; Elkahoui, S.; Limam, F.; Tabbene, O. Antifungal mechanism of the combination of Cinnamomum verum and Pelargonium graveolens essential oils with fluconazole against pathogenic Candida strains. Appl. Microbiol. Biotechnol. 2017, 101, 6993–7006. [Google Scholar] [CrossRef]
- Carson, C.F.; Hammer, K.A.; Riley, T.V. Melaleuca alternifolia (Tea Tree) Oil: A Review of Antimicrobial and Other Medicinal Properties. Clin. Microbiol. Rev. 2006, 19, 50–62. [Google Scholar] [CrossRef] [PubMed]
- Rajkowska, K.; Nowicka-Krawczyk, P.; Kunicka-Styczyńska, A. Effect of Clove and Thyme Essential Oils on Candida Biofilm Formation and the Oil Distribution in Yeast Cells. Molecules 2019, 24, 1954. [Google Scholar] [CrossRef] [PubMed]
- Manoharan, R.K.; Lee, J.-H.; Lee, J. Antibiofilm and Antihyphal Activities of Cedar Leaf Essential Oil, Camphor, and Fenchone Derivatives against Candida albicans. Front. Microbiol. 2017, 8, 1476. [Google Scholar] [CrossRef]
- Brown, M.R.; Richards, R.M. Effect of Polysorbate (Tween) 80 on the resistance of Pseudomonas aeruginosa to chemical inactivation. J. Pharm. Pharmacol. 1964, 16, 51T–55T. [Google Scholar] [CrossRef] [PubMed]
- Shoja, M.; Minai-Tehrani, D. Effect of Tween Type Non-Ionic Detergent on the Activity of Lipase of Pseudomonas aeruginosa. Cell Biophys. 2021, 79, 87–92. [Google Scholar] [CrossRef]
- Marchese, A.; Barbieri, R.; Coppo, E.; Orhan, I.E.; Daglia, M.; Nabavi, S.M.; Izadi, M.; Abdollahi, M.; Ajami, M. Antimicrobial activity of eugenol and essential oils containing eugenol: A mechanistic viewpoint. Crit. Rev. Microbiol. 2017, 43, 668–689. [Google Scholar] [CrossRef]
- Toutain-Kidd, C.M.; Kadivar, S.C.; Bramante, C.T.; Bobin, S.A.; Zegans, M.E. Polysorbate 80 Inhibition of Pseudomonas aeruginosa Biofilm Formation and Its Cleavage by the Secreted Lipase LipA. Antimicrob. Agents Chemother. 2008, 53, 136–145. [Google Scholar] [CrossRef]
- Gulati, M.; Nobile, C.J. Candida albicans biofilms: Development, regulation, and molecular mechanisms. Microbes Infect. 2016, 18, 310–321. [Google Scholar] [CrossRef]
- Mello, T.P.; Oliveira, S.S.C.; Frasés, S.; Branquinha, M.H.; Santos, A.L.S. Surface properties, adhesion and biofilm formation on different surfaces by Scedosporium spp. and Lomentospora prolificans. Biofouling 2018, 34, 800–814. [Google Scholar] [CrossRef]
- Junka, A.F.; Żywicka, A.; Szymczyk, P.; Dziadas, M.; Bartoszewicz, M.; Fijałkowski, K.A.D.A.M. test (Antibiofilm Dressing’s Activity Measurement)—Simple method for evaluating anti-biofilm activity of drug-saturated dressings against wound pathogens. J. Microbiol. Methods 2017, 143, 6–12. [Google Scholar] [CrossRef]
- Maczynska, B.; Secewicz, A.; Smutnicka, D.; Szymczyk, P.; Dudek-Wicher, R.; Junka, A.; Bartoszewicz, M. In vitro efficacy of gentamicin released from collagen sponge in eradication of bacterial biofilm preformed on hydroxyapatite surface. PLoS ONE 2019, 14, e0217769. [Google Scholar] [CrossRef] [PubMed]
- Ciecholewska-Juśko, D.; Żywicka, A.; Junka, A.; Drozd, R.; Sobolewski, P.; Migdał, P.; Kowalska, U.; Toporkiewicz, M.; Fijałkowski, K. Superabsorbent crosslinked bacterial cellulose biomaterials for chronic wound dressings. Carbohydr. Polym. 2021, 253, 117247. [Google Scholar] [CrossRef] [PubMed]
- A Website of American Type Cell Collection. The US of P. aeruginosa Reference Strain. Pseudomonas Aeruginosa (ATCC® 15442™). Available online: https://www.lgcstandards-atcc.org/Products/All/15442?geo_country=pl (accessed on 20 April 2021).
- Novais, J.S.; Moreira, C.S.; Silva, A.C.J.; Loureiro, R.S.; Figueiredo, A.M.S.; Ferreira, V.F.; Castro, H.C.; Da Rocha, D.R. Antibacterial naphthoquinone derivatives targeting resistant strain Gram-negative bacteria in biofilms. Microb. Pathog. 2018, 118, 105–114. [Google Scholar] [CrossRef] [PubMed]
- De Rienzo, M.D.; Stevenson, P.; Marchant, R.; Banat, I. Pseudomonas aeruginosa biofilm disruption using microbial surfactants. J. Appl. Microbiol. 2016, 120, 868–876. [Google Scholar] [CrossRef] [PubMed]
- Guerin-Mechin, L.; Dubois-Brissonnet, F.; Heyd, B.; Leveau, J.Y. Specific variations of fatty acid composition of Pseudomonas aeruginosa ATCC 15442 induced by Quaternary Ammonium Compounds and relation with resistance to bactericidal activity. J. Appl. Microbiol. 1999, 87, 735–742. [Google Scholar] [CrossRef]
- Hammann, A.; Huebner, N.-O.; Bender, C.; Ekkernkamp, A.; Hartmann, B.; Hinz, P.; Kindel, E.; Koban, I.; Koch, S.; Kohlmann, T.; et al. Antiseptic Efficacy and Tolerance of Tissue-Tolerable Plasma Compared with Two Wound Antiseptics on Artificially Bacterially Contaminated Eyes from Commercially Slaughtered Pigs. Ski. Pharmacol. Physiol. 2010, 23, 328–332. [Google Scholar] [CrossRef]
- Pitten, F.-A.; Werner, H.-P.; Kramer, A. A standardized test to assess the impact of different organic challenges on the antimicrobial activity of antiseptics. J. Hosp. Infect. 2003, 55, 108–115. [Google Scholar] [CrossRef]
- Junka, A.; Szymczyk, P.; Ziółkowski, G.; Karuga-Kuzniewska, E.; Smutnicka, D.; Bil-Lula, I.; Bartoszewicz, M.; Mahabady, S.; Sedghizadeh, P.P. Bad to the Bone: On In Vitro and Ex Vivo Microbial Biofilm Ability to Directly Destroy Colonized Bone Surfaces without Participation of Host Immunity or Osteoclastogenesis. PLoS ONE 2017, 12, e0169565. [Google Scholar] [CrossRef]
- Chen, X.; Thomsen, T.R.; Winkler, H.; Xu, Y. Influence of biofilm growth age, media, antibiotic concentration and exposure time on Staphylococcus aureus and Pseudomonas aeruginosa biofilm removal in vitro. BMC Microbiol. 2020, 20, 1–11. [Google Scholar] [CrossRef] [PubMed]
- Meißner, A.; Hasenclever, D.; Brosteanu, O.; Chaberny, I.F. EFFECT of daily antiseptic body wash with octenidine on nosocomial primary bacteraemia and nosocomial multidrug-resistant organisms in intensive care units: Design of a multicentre, cluster-randomised, double-blind, cross-over study. BMJ Open 2017, 7, e016251. [Google Scholar] [CrossRef] [PubMed]
- Junka, A.; Bartoszewicz, M.; Smutnicka, D.; Secewicz, A.; Szymczyk, P. Efficacy of antiseptics containing povidone-iodine, octenidine dihydrochloride and ethacridine lactate against biofilm formed byPseudomonas aeruginosaandStaphylococcus aureusmeasured with the novel biofilm-oriented antiseptics test. Int. Wound J. 2013, 11, 730–734. [Google Scholar] [CrossRef] [PubMed]
- Krasowski, G.; Junka, A.; Paleczny, J.; Czajkowska, J.; Makomaska-Szaroszyk, E.; Chodaczek, G.; Majkowski, M.; Migdał, P.; Fijałkowski, K.; Kowalska-Krochmal, B.; et al. In Vitro Evaluation of Polihexanide, Octenidine and NaClO/HClO-Based Antiseptics against Biofilm Formed by Wound Pathogens. Membranes 2021, 11, 62. [Google Scholar] [CrossRef] [PubMed]
- Lucero, M.; Estell, R.; Tellez, M.; Fredrickson, E. A retention index calculator simplifies identification of plant volatile organic compounds. Phytochem. Anal. 2009, 20, 378–384. [Google Scholar] [CrossRef]
- Standard Reference Data Program of the National Institute of Standards and Technology. The NIST Mass Spectral Search Program for the NIST/EPA/NIH EI and NIST Tandem Spectral Library; Standard Reference Data Program of the National Institute of Standards and Technology: Gaithersburg, MD, USA, 2017.
- Mondello, L. Mass Spectra of Flavors and Fragrances of Natural and Synthetic Compounds, 3rd ed.; Wiley: Hoboken, NJ, USA, 2015. [Google Scholar]
- Adams, R.P. Identification of Essential Oil Components by Gas Chromatography/Mass Spectrometry, 4th ed.; Allured Pub Corp: Carol Stream, IL, USA, 2017. [Google Scholar]

| Zones of Growth Inhibition [mm] | ||||||||
|---|---|---|---|---|---|---|---|---|
| F-EO | G-EO | Tt-EO | C-EO | CW-EO | OCT | ATB * | DMSO | |
| S. aureus | 0 (±0) | 9 (±0) | 16 (±1) | 7 (±0) | 1 (±0) | 8 (±0) | 16(±0) | 0 (±0) |
| E. faecalis | 0 (±0) | 6 (±0) | 16 (±1) | 7 (±0) | 1 (±0) | 7.33 (±0.47) | 12 (±0) | 0 (±0) |
| P. aeruginosa | 0 (±0) | 7 (±0) | 7 (±0) | 6 (±0) | 1 (±0) | 7.66 (±0.47) | 32(±0) | 0 (±0) |
| K. pneumoniae | 0 (±0) | 8.33 (±0.47) | 11.66 (±0.47) | 6 (±0) | 1 (±0) | 7.66 (±0.47) | 23 (±0.47) | 0 (±0) |
| E. coli | 0 (±0) | 6 (±0) | 12.66 (±0.47) | 6 (±0) | 1 (±0) | 7.66 (±0.47) | 38 (±0.47) | 0 (±0) |
| C. albicans | 25 (±0) | 6 (±0) | 18 (±0) | 7 (±0) | 1 (±0) | 8 (±0.82) | 26 (±0) | 0 (±0) |
| MIC [%] | |||||||||||
|---|---|---|---|---|---|---|---|---|---|---|---|
| F-EO | F-EOem | G-EO | G-EOem | Tt-EO | Tt-EOem | C-EO | C-EOem | CW-EO | CW-EOem | OCT | |
| S. aureus | 100 | 100 | 12.5 | 0.195 | 0.78 | 0.39 | 0.195 | 0.195 | 0.195 | 0.195 | 0.39 |
| E. faecalis | 100 | 100 | 12.5 | 0.39 | 1.56 | 6.25 | 0.195 | 0.195 | 25 | 12.5 | 0.195 |
| P. aeruginosa | 100 | 100 | 12.5 | 50 | 1.56 | 1.56 | 3.125 | 0.195 | 50 | 100 | 0.78 |
| K. pneumoniae | 100 | 100 | 6.25 | 50 | 0.78 | 3.125 | 0.195 | 0.195 | 100 | 100 | 0.195 |
| E. coli | 100 | 100 | 6.25 | 0.195 | 0.78 | 0.39 | 0.195 | 0.195 | 50 | 100 | 0.39 |
| C. albicans | 100 | 100 | 12.5 | 6.25 | 3.125 | 0.39 | 0.195 | 0.195 | 0.195 | 50 | 0.1 |
Publisher’s Note: MDPI stays neutral with regard to jurisdictional claims in published maps and institutional affiliations. |
© 2021 by the authors. Licensee MDPI, Basel, Switzerland. This article is an open access article distributed under the terms and conditions of the Creative Commons Attribution (CC BY) license (https://creativecommons.org/licenses/by/4.0/).
Share and Cite
Dudek-Wicher, R.; Paleczny, J.; Kowalska-Krochmal, B.; Szymczyk-Ziółkowska, P.; Pachura, N.; Szumny, A.; Brożyna, M. Activity of Liquid and Volatile Fractions of Essential Oils against Biofilm Formed by Selected Reference Strains on Polystyrene and Hydroxyapatite Surfaces. Pathogens 2021, 10, 515. https://doi.org/10.3390/pathogens10050515
Dudek-Wicher R, Paleczny J, Kowalska-Krochmal B, Szymczyk-Ziółkowska P, Pachura N, Szumny A, Brożyna M. Activity of Liquid and Volatile Fractions of Essential Oils against Biofilm Formed by Selected Reference Strains on Polystyrene and Hydroxyapatite Surfaces. Pathogens. 2021; 10(5):515. https://doi.org/10.3390/pathogens10050515
Chicago/Turabian StyleDudek-Wicher, Ruth, Justyna Paleczny, Beata Kowalska-Krochmal, Patrycja Szymczyk-Ziółkowska, Natalia Pachura, Antoni Szumny, and Malwina Brożyna. 2021. "Activity of Liquid and Volatile Fractions of Essential Oils against Biofilm Formed by Selected Reference Strains on Polystyrene and Hydroxyapatite Surfaces" Pathogens 10, no. 5: 515. https://doi.org/10.3390/pathogens10050515
APA StyleDudek-Wicher, R., Paleczny, J., Kowalska-Krochmal, B., Szymczyk-Ziółkowska, P., Pachura, N., Szumny, A., & Brożyna, M. (2021). Activity of Liquid and Volatile Fractions of Essential Oils against Biofilm Formed by Selected Reference Strains on Polystyrene and Hydroxyapatite Surfaces. Pathogens, 10(5), 515. https://doi.org/10.3390/pathogens10050515

